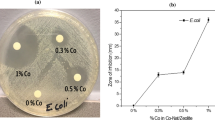

Abstract
This paper investigates the potential of using the silver antibacterial properties combined with the metal ion exchange characteristics of silver-modified clinoptilolite to produce a treatment system capable of removing both contaminants from aqueous streams. The results have shown that silver-modified clinoptilolite is capable of completely eliminating Escherichia coli after 30-min contact time demonstrating its effectiveness as a disinfectant. Systems containing both E. coli and metals exhibited 100 % E. coli reduction after 15-min contact time and maximum metal adsorption removal efficiencies of 97, 98, and 99 % for Pb2+, Cd2+, and Zn2+ respectively after 60 min; 0.182–0.266 mg/g of metal ions were adsorbed by the zeolites in the single- and mixed-metal-containing solutions. Nonmodified clinoptilolite showed no antibacterial properties. This study demonstrated that silver-modified clinoptilolite exhibited high disinfection and heavy metal removal efficiencies and consequently could provide an effective combined treatment system for the removal of E. coli and metals from contaminated water streams.
Similar content being viewed by others
Explore related subjects
Discover the latest articles, news and stories from top researchers in related subjects.Avoid common mistakes on your manuscript.
Introduction
Pathogenic microorganisms and persistent nonbiodegradable heavy metals present in wastewater are detrimental to human health and the ecosystem hence the need for adequate wastewater treatment before reuse or discharge into surface water bodies (Erdem et al. 2004; Sprynskyy et al. 2006; WHO 2011; Pathak and Gopal 2012).
Natural and modified zeolites have been used extensively as adsorbents in water and wastewater treatment applications for the removal of metal ions due to their high exchange capacities, environmental compatibility, availability, and cost-effectiveness. Clinoptilolite is one of the most commonly used natural zeolites and is highly selective towards metal ions such as Pb2+, Cd2+, and Zn2+ removal as shown in several studies where high metal removal efficiencies and adsorption capacities have been achieved (Ouki et al. 1993; Inglezakis et al. 2002; Bektas and Kara 2004; Erdem et al. 2004; Sprynskyy et al. 2006; Wang and Peng 2010).
Silver is a known antibacterial agent, which has been used in different applications including water purification (Feng et al. 2000; Silvestry-Rodriguez et al. 2007; Pathak and Gopal 2012; Lemire et al. 2013). A major area of interest has been the incorporation of silver ions and nanoparticles into inert support materials from which they are released (Bogdanchikova et al. 2000; Rivera-Garza et al. 2000; Top and Ulku 2004; Bandyopadhyaya et al. 2008; De la Rosa Gomez et al. 2008a, b, 2010; Kwakye-Awuah et al. 2008; Copcia et al. 2011; Shameli et al. 2011a, b; Guerra et al. 2012; Krishnani et al. 2012). Natural zeolites are good support materials for silver ions due to their nonreactive nature and good silver exchange properties (Copcia et al. 2011). The antibacterial activity of silver-modified zeolites against microorganisms in different aqueous media has been investigated and reported in literature (Rivera-Garza et al. 2000; De la Rosa Gomez et al. 2008a, b, 2010; Kwakye-Awuah et al. 2008; Copcia et al. 2011; Krishnani et al. 2012). In some studies, complete elimination of microorganisms including Escherichia coli suspended in water was achieved within 1 to 2 h of treatment with silver-modified clinoptilolite (SZ) under varying experimental conditions (Rivera-Garza et al. 2000; De la Rosa Gomez et al. 2008b). The antibacterial activity of silver-modified zeolites is a function of silver ions released into the aqueous medium from the zeolites which penetrate the bacterial cell wall, damage the cell DNA, and impair the cells ability to replicate eventually resulting in cell death (Rivera-Garza et al. 2000; De la Rosa Gomez et al. 2008a, b; Copcia et al. 2011; Lemire et al. 2013).
In a recent study, the performance of silver ion-exchanged zeolites for the combined removal of a range of microorganisms including E. coli and ammonia from liquid media was investigated with results suggesting potential application in aquaculture management (Krishnani et al. 2012). However, a survey of the literature reveals that most studies have focused solely on the antibacterial properties of silver-modified zeolites with the zeolite acting as an inert carrier and releaser of silver ions (Rivera-Garza et al. 2000; De la Rosa Gomez et al. 2008a, b, 2010; Copcia et al. 2011), thus highlighting the need for research focused on the optimal utilization of these silver-modified zeolites by taking advantage of their dual treatment capabilities. The inherent heavy metals adsorption properties of the natural zeolite and the acquired disinfection properties due to the silver ions incorporated can be investigated and optimized to develop an effective wastewater treatment unit process capable of simultaneously handling bacterial and heavy metals contamination. It is therefore important to investigate the performance of this material under controlled conditions with a view to extending its application to real wastewater streams.
Therefore, the aim of this study was to investigate the potential use of SZ for the simultaneous removal of E. coli as an indicator of fecal contamination and metal ions (Pb2+, Zn2+, and Cd2+) from aqueous solutions to produce a treatment system capable of removing both contaminants from aqueous streams.
Materials and methods
Materials
Natural clinoptilolite (NZ) was purchased from Planet Care Products, UK. The particle size fraction at 0.212–0.600 mm was selected for use, washed to remove surface dust, dried overnight in an oven at 60 °C, and stored until needed.
Analytical-grade reagents were used to prepare standard stock solutions in deionized water for use in the study. AgNO3 was purchased from Sigma Aldrich, UK and Pb (NO3)2, CdN2O64H2O, and Zn(NO3)2 · 6H2O were purchased from Fisher Scientific, UK. HNO3 (trace analysis grade) was used for pH adjustment. Nutrient broth and Ringer’s solution tablets were purchased from Oxoid, UK.
Microorganism and media preparation
E. coli NCTC 9001 (Public Health England culture collection) used in this batch of experiments was grown overnight in nutrient broth (Oxoid, UK) at 37 °C. The cells were separated and washed by centrifugation and resuspended in deionized water at 1010 colony forming units (CFU)/100 ml. Ringer’s solution tablet (Oxoid, UK) was used to prepare one quarter strength Ringer’s solution for serial dilutions, and m-lauryl sulfate broth (Sigma Aldrich, UK) was used for enumeration of coliforms by membrane filtration. All media were prepared according to manufacturer’s instructions and autoclaved at 120 °C for 20 min.
Preparation of silver-modified clinoptilolite
Silver modification of clinoptilolite was achieved using the ion exchange method; 100 g of NZ was suspended in 250 ml 3 % (w/v) AgNO3 solution at pH 5 ± 0.2 (to prevent metal precipitation) and shaken at 300 rpm for 24 h in a dark room (due to the light sensitivity of silver) to achieve maximum exchange of silver onto the zeolites. The zeolites were separated from the solution by filtration, washed with deionized water dried overnight at 60 °C, and stored ready for use. The silver content of the modified zeolite was determined to be 43.4 mg/g.
Characterization of natural and silver-modified clinoptilolite samples
The NZ and SZ samples were characterized by powder X-ray diffraction (XRD; PANalytical Powder Instrument) to identify the phase composition of the samples. The diffractogram patterns obtained were compared with the recorded patterns from the International Centre for Diffraction Data (ICDD) database. The surface morphology and elemental composition of the samples were analyzed using a Hitachi S3200N scanning electron microscope equipped with an energy dispersive X-ray detector (SEM-EDX). The Brunauer–Emmett–Teller (BET) surface area of the samples was measured by nitrogen adsorption at 77 K using a BET surface area analyzer (Micromeritics Gemini).
Disinfection
0.2 g of SZ and NZ were suspended in 100-ml solutions of E. coli in deionized water (1010 CFU/100 ml). The pH was adjusted to 5 ± 0.2 (to maintain the same conditions as in the E. coli-metal(s) solutions where metal precipitation had to be avoided), and the solutions were shaken at 300 rpm for 0–60 min. Negative control solutions without zeolites were tested under the same experimental conditions as the zeolite treated samples.
Combined disinfection and metal removal
The disinfection and metal removal efficiencies of the zeolites were simultaneously investigated as a function of contact time; 0.2 g of SZ and NZ were suspended in 100 ml E. coli-metal(s) solutions (E. coli-Pb, E. coli-Cd, E. coli-Zn, and E. coli-Pb-Cd-Zn). The initial concentration of E. coli was 1010 CFU/100 ml and the initial metal concentrations were 0.4 mg/l Pb, 0.5 mg/l Cd, and 0.5 mg/l Zn. The composition of wastewater varies depending on the source, however high pollutant concentrations were used in this study in order to challenge the system. The pH was adjusted to 5 ± 0.2 to avoid metal precipitation, and the solutions were shaken at 300 rpm for 0–60 min. Negative control solutions without zeolites were tested under the same experimental conditions as the zeolite-treated samples.
Analysis of treated solutions
At the end of each run, the final pH of the treated solution was measured. Enumeration of bacterial colonies was performed using the membrane filtration method (APHA 1992). From each sample, 0.1 ml was taken out and a set of serial dilutions were made using one quarter strength Ringer’s solution, passed through 0.45 μm membrane filters, placed on pads saturated with m-lauryl sulfate broth, and incubated overnight at 37 °C. The CFU were counted and recorded as CFU/100 ml.
The remaining solution was filtered using 0.45 μm syringe filters, acidified to pH <2, and kept in the refrigerator for metal analysis.
The concentration of metal ions (Ag2+, Pb2+, Cd2+, and Zn2+) in the treated solutions was determined by inductively coupled plasma-optical emission spectrometry (ICP-OES; Perkin Elmer Optima 5300 DV).
The percent metal removal was calculated with the following equation:
Where C o and C e are the initial and final metal concentrations (mg/l) in the solutions, respectively. The amount of metal ion adsorbed per unit mass of zeolite (Q e) was calculated with the following equation:
Where V and m are the volume of solution (L) and mass of zeolite (g), respectively. All experiments were performed in duplicates, and mean values are reported.
Results and discussion
Characterization
The SEM images and EDX spectra of the zeolite samples are shown in Fig. 1. In the SEM images, the characteristic morphology of clinoptilolite can be observed in the highly porous structure and monoclinic symmetry of the platy crystals in the NZ and SZ (Mumpton and Ormsby 1976; De la Rosa Gomez et al. 2008a, b; Copcia et al. 2011). However, there are no observed changes in the surface morphology of the zeolites after silver modification. The EDX spectra indicate the presence of silver ions in the SZ. The elemental composition of the zeolite samples as seen in Table 1 shows that the Ag2+ were mainly exchanged for the Na+ present in the NZ.
The XRD patterns of the NZ and SZ samples shown in Fig. 2 match the ICDD reference pattern for clinoptilolite. There is no difference in the peak patterns, and their positions in the natural and modified samples indicating that the crystal structure of the clinoptilolite was unchanged after silver modification (De la Rosa Gomez et al. 2008b). However, there were changes in the relative peak intensities, which could be attributed to the additional cationic species (silver ions) in the channels of the zeolite (Rivera-Garza et al. 2000; Concepcion-Rosabal et al. 2005; De la Rosa Gomez et al. 2008a, b). BET surface area analysis of the zeolite samples showed that silver modification of the NZ resulted in a reduction in surface area from 57.06 to 14.44 m2/g for NZ and SZ respectively due to the incorporation of silver ions into the zeolite during the ion exchange process.
Effect of silver modification on E. coli removal
The antibacterial activity of the SZ in deionized water containing E. coli as a function of contact time was investigated and E. coli (log CFU/100 ml) versus time for NZ- and SZ-treated samples and controls are shown in Fig. 3. The results show that SZ exhibited antibacterial activity towards E. coli with a 4 log (99.99 %) reduction within 5 min and complete disinfection (100 %) achieved after 30 min of contact time. The amount of silver released by SZ increased as the number of viable cells decreased in the solution and a total concentration of 0.76 mg/l of silver (0.9 % of Ag2+ in SZ) was released into the solution at the time of complete disinfection (30 min) and 1.10 mg/l (1.2 % of Ag2+ in SZ) was released at the end of the experiment (after 60 min of contact). On the contrary NZ did not exhibit any antibacterial activity as similarly observed in other studies (Rivera-Garza et al. 2000; De la Rosa Gomez et al. 2008b; Copcia et al. 2011). The higher E. coli survival rate (80 %) observed after 60 min compared with the control solution could be due to the presence of essential elements for microbial growth such as the exchangeable Na+ in the NZ (De la Rosa Gomez et al. 2010; Copcia et al. 2011). In the control solution, there was still a high survival rate (90 %) after 30 min of contact time with only 1 log reduction compared with the SZ-treated solution, where all cells had been eliminated. However, a remarkable reduction (6 log reduction) in the number of viable bacteria cells was observed after 60 min of contact. This could be attributed to the combined effects of starvation due to the absence of essential nutrients and osmotic shock. The latter may have occurred due to the hypotonic environment in the deionized water solutions resulting in cell lysis (Record Jr. et al. 1998; Van Grieken et al. 2010). This also suggests that osmotic stress may have contributed to cell death in the SZ-treated solutions albeit to a lesser extent when the concentration of E. coli cells in SZ-treated and control solutions are compared within the 15 to 30 min contact period as shown in Fig. 4.
These results indicate that the disinfection efficiency of the SZ is a function of contact time, amount of silver ions released into the solution (Rivera-Garza et al. 2000; De la Rosa Gomez et al. 2010; Copcia et al. 2011). The silver ions penetrate the cell wall resulting in the cytoplasmic membrane detachment and deposition of ions in the cell DNA and around the cell wall. The silver ions interact with the cell DNA causing damage, inactivation of cell proteins due to reactions with the thiol groups, and inhibition of essential cell respiratory enzymes resulting in the generation of reactive oxygen species. These processes lead to loss of replication ability and cell death (Feng et al. 2000; Matsumara et al. 2003; Jung et al. 2008; Copcia et al. 2011; Lemire et al. 2013).
E. coli removal from combined systems
Further experiments were carried out to investigate the effect of metal ions on the disinfection efficiency of the zeolites and the ability of the SZ to simultaneously eliminate pathogens and remove metals from the solutions. The graphs in Fig. 4 show the disinfection performance of the zeolites in different combined E. coli-metal(s) solutions and the amount of silver released by SZ into the solutions as a function of time.
SZ exhibited antibacterial activity towards the E. coli in the different E. coli-metal(s) solutions with complete elimination (100 %) of bacterial cells after 15 min of contact. Comparing the performance of SZ in the E. coli and E. coli-metal(s) solutions, the rate of disinfection of E. coli in the presence of metal ions was two times faster than that observed in the E. coli only solution where 30 min of contact time was required to achieve complete (100 %) disinfection. These results indicate that the presence of metal ions accelerated the disinfection process as the amount of silver released by the SZ into the solutions increased compared with the concentration in the E. coli only solution due to ion exchange between the metal ions in solution and the silver ions in the zeolite. The amount of silver released into the solutions after 15 min contact and complete disinfection were 1.05, 0.82, 1.39, and 1.33 mg/l in the E. coli-Pb, E. coli-Cd E. coli-Zn, and E. coli-Pb-Cd-Zn solutions, respectively. The differences in the amount of silver released in the E. coli-metal(s) solutions may be due to several factors including the complexity of system interactions occurring in the different matrices and variations in the actual silver ion content of the different SZ fractions agitated in each solution due to the heterogeneity of clinoptilolite (Sprynskyy et al. 2010), which influences metal adsorption and desorption. According to the WHO (2011), though there is no health-based limit for silver in water, up to 0.1 mg/l can be tolerated without any health risks. Thus, silver recovery and reuse in multicolumn treatment systems are being investigated as part of ongoing work.
There was no significant reduction (up to 90 % survival) in viable cells in the NZ-treated E. coli-metal(s) solutions as similarly observed in the E. coli only solutions as the metal ions were simultaneously sorbed by the NZ, and thus they did not have any remarkable effect on the bacterial cells in the water. Similarly in the control solutions, there was only a slight reduction (1–2 log) in bacterial cells after 60 min in the solutions including the E. coli-Pb-Cd-Zn solution where the total metal concentration was 1.5 mg/l. Metal ions are known to exhibit levels of toxicity towards bacterial cells (Top and Ulku 2004; Hrenovic et al. 2012; Lemire et al. 2013) Minimum inhibitory concentrations of metal ions against E. coli determined on agar medium ranging from 0.5 to 5 mM (corresponding to 0.05–1.04 mg/l) have been reported (Nies 1999; Spain et al. 2003). The results of the control experiments indicate that under the specific experimental conditions in this study and within the contact time observed the concentration of metals tested did not result in a remarkable decrease in bacterial cells. This further confirms that the reduction in viable cells in the SZ-treated solutions was mainly due to the antibacterial activity of the silver ions released by the zeolites into the solution.
Metals removal from combined systems
The adsorption capacities and removal efficiencies of the zeolites in the E. coli-metal(s) solutions were investigated and results depicted in Fig. 5. There was rapid uptake of metal ions within the first 15 min of contact with high metal removal efficiencies of 90–99 % achieved by the natural and silver-modified zeolites after 60 min of contact time. Several authors have reported high metal removal efficiencies for natural and pre-treated clinoptilolite and other zeolites for the removal of Pb, Cd, and Zn from solutions (Ouki et al. 1993; Bektas and Kara 2004; Erdem et al. 2004; Sprynskyy et al. 2006; Gedik and Imamoglu 2008; Wang and Peng 2010). The maximum metal adsorption capacities of SZ and NZ were in the range of 0.182–0.189, 0.224–0.240 mg/g, and 0.245–0.266 mg/g for Pb, Cd, and Zn respectively in the single and mixed metals containing solutions. The ongoing disinfection of E. coli by the silver ions being released from the SZ and the presence of other metal ions in the solutions did not affect the removal efficiencies which indicate that competition in the multicomponent systems for adsorption/exchange sites was insignificant. The removal of metal ions involves the mechanisms of ion exchange in the zeolitemicropores and adsorption on the mineral surfaces. Metal removal occurs as the solutions are agitated, resulting in increased interphase mass transfer of metal ions from the liquid to the solid phase (Bektas and Kara 2004; Erdem et al. 2004). The metal adsorption kinetics for the different solutions were investigated with the pseudo- and pseudo-second-order kinetic models. The linear form of the pseudo-first-order kinetic model is expressed as (Gupta and Bhattacharyya 2011):
The linear form of the pseudo-second order kinetic model is expressed as (Gupta and Bhattacharyya 2011):
where q e and q t are the amount of metal ions adsorbed per unit mass of zeolite (mg/g) at equilibrium and time t respectively and k 1 is the pseudo-first-order adsorption rate constant (min−1) and k 2 is the pseudo-second-order adsorption rate constant (g mg−1 min−1).
The kinetics of metal adsorption is a function of experimental conditions and the characteristics of the adsorbent (Bektas and Kara 2004; Gupta and Bhattacharyya 2011). The kinetic constants and correlation coefficients for the E. coli-metal(s) solutions are shown in Table 2. The correlation coefficients for the pseudo-second-order model are higher indicating that it is a better description of the heavy metals removal kinetics. In the control solutions, there was a slight reduction in metal concentrations (3–14 %) which could be mainly due to metal ion uptake by the bacterial cells. The results also showed that the addition of SZ and NZ to the solutions resulted in a pH increase from 5 to an average of 6.3 due to zeolite hydrolysis and uptake of H+ ions from the solutions by the zeolites (Bektas and Kara 2004; Gunay et al. 2007).
Conclusions
This study has shown that SZ completely eliminated (100 % removal) E. coli within 15–30 min contact time. The disinfection efficiency was not inhibited by the presence of metal ions in the solution with metal removal efficiencies of more than 90 % being achieved. NZ samples did not exhibit antibacterial activity in both the E. coli and E. coli-metal(s) combined solutions. In control solutions containing no zeolites, there was a reduction in viable bacterial cells after 60 min of contact due to the absence of nutrients and possibly osmotic stress as a result of the hypotonic nature of the deionized water solutions. Osmotic stress may also have contributed to a lesser extent to cell death in the SZ-treated samples. Thus, studies are under way to investigate the performance of this material in real wastewater samples, the effects of different experimental variables, and silver recovery and reuse in multicolumn systems. This study has demonstrated that silver-modified clinoptilolite could potentially be used as a disinfecting adsorbent for the removal of E. coli and heavy metals from wastewater providing a one-step treatment process.
References
APHA (1992) Standard methods for the examination of water and wastewater, 18th edn. American Public Health Association, Maryland
Bandyopadhyaya R, Sivaiah MV, Shankar PA (2008) Technical note: silver-embedded granular activated carbon as an antibacterial medium for water purification. J Chem Technol Biotechnol 83:1177–1180
Bektas N, Kara S (2004) Removal of lead from aqueous solutions by natural clinoptilolite: equilibrium and kinetic studies. Sep Purif Technol 39:189–200
Bognachikova N, Concepcion-Rosabal B, Petranovskii V, Avalos Boja M, Rodriguez-Fuentes G (2000) Microbicide effect of Ag-clinoptilolites, part 1: preparation and investigation of the structure of samples containing silver in different states, Complex Mediums. In: Proceedings of SPIE 4097, San Diego, CA, 30, June 2000: 322–329
Concepcion-Rosabal B, Rodriguez-Fuentes G, Bogdanchikova N, Bosch P, Avalos P, Lara VH (2005) Comparative study of natural and synthetic clinoptilolites containing silver in different states. Microporous Mesoporous Mater 86:249–255
Copcia VE, Luchian C, Dunca S, Bilba N, Hristodor CM (2011) Antibacterial activity of silver-modified natural clinoptilolite. J Mater Sci 46:7121–7128
De la Rosa GI, Olguin MT, Alcantara D (2008a) Antibacterial behaviour of silver-modified clinoptilolite-heulandite rich tuff on coliform microorganisms from wastewater in a column system. J Environ Manag 40:853–863
De la Rosa GI, Olguin MT, Alcantara D (2008b) Bactericides of coliform microorganisms from wastewater using silver-clinoptilolite rich tuffs. Appl Clay Sci 40:45–53
De la Rosa GI, Olguin MT, Alcantara D (2010) Silver-modified Mexican clinoptilolite-rich tuffs with various particle sizes as antimicrobial agents against Escherichia coli. J Mex Chem Soc 54:139–142
Erdem E, Karapinar N, Donat R (2004) The removal of heavy metal cations by natural zeolites. J Colloid Interface Sci 280:309–314
Feng QL, Wu J, Chen GQ, Cui FZ, Kim TN, Kim JO (2000) A mechanistic study of the antibacterial effect of silver ions on Escherichia coli and Staphylococcus aureus. J Biomed Mater Res 52:662–668
Gedik K, Imamoglu I (2008) Removal of cadmium from aqueous solutions using clinoptilolite: influence of pretreatment and regeneration. J Hazard Mater 155:385–392
Guerra R, Lima E, Viniegra M, Guzman A, Lara V (2012) Growth of Escherichia coli and Salmonella typhi inhibited by fractal silver nanoparticles supported on zeolites. Microporous Mesoporous Mater 147:267–273
Gunay A, Arslankaya E, Tosun I (2007) Lead removal from aqueous solution by natural and pretreated clinoptilolite: adsorption equilibrium and kinetics. J Hazard Mater 146:362–371
Gupta SS, Bhattacharyya KG (2011) Kinetics of adsorption of metal ions on inorganic materials: a review. Adv Colloid Interface 162:39–58
Hrenovic J, Milenkovic J, Ivankovic T, Rajic N (2012) Antibacterial activity of heavy metal-loaded natural zeolite. J Hazard Mater 201–202:260–264
Inglezakis VJ, Loizidou MD, Grigoropoulou HP (2002) Equilibrium and Kinetic ion exchange studies of Pb2+, Cr3+, Fe3+ and Cu2+ on natural clinoptilolite. Water Res 36:2784–2792
Jung WK, Koo HC, Kim KW, Shim S (2008) Antibacterial activity and mechanism of action of the silver ion in Staphylococcus aureus and Escherichia coli. Appl Environ Microbiol 74:2171–2178
Krishnani KK, Zhang Y, Xiong L, Yan Y, Boopathy R, Mulchandani A (2012) Bactericidal and ammonia removal activity of silver ion-exchanged zeolite. Bioresource Technol 117:86–91
Kwakye-Awuah B, Williams C, Kenward MA, Radecka I (2008) Antimicrobial action and efficiency of silver loaded zeolite X. J Appl Microbiol 104:1516–1524
Lemire JA, Harrison JJ, Turner RJ (2013) Antimicrobial activity of metals: mechanisms, molecular targets and applications. Nat Rev Microbiol 11:371–384
Matsumara Y, Yoshikata K, Kunisaki S, Tsuchido T (2003) Mode of Bactericidal action of Silver Zeolite and its comparison with that of Silver Nitrate. Appl Environ Microbiol 69:4278–4281
Mumpton FA, Ormsby AC (1976) Morphology of zeolites in sedimentary rocks by scanning electron microscopy. Clays Clay Mineral 24:1–23
Nies DH (1999) Microbial heavy-metal resistance. Appl Microbiol Biotechnol 51:730–750
Ouki S, Cheeseman C, Perry R (1993) Effects of conditioning and treatment of chabazite and clinoptilolite prior to lead and cadmium removal. Environ Sci Technol 27:1108–1116
Pathak Satya P, Gopal K (2012) Evaluation of bactericidal efficacy of silver ions on Escherichia coli for drinking water disinfection. Environ Sci Pollut Res 19:2285–2290
Record MT Jr, Courtenay ES, Cayley DS, Guttman HJ (1998) Responses of E. coli to osmotic stress: large changes in amounts of cytoplasmic solutes and water. Trends Biochem Sci 23:143–148
Rivera-Garza M, Olguin MT, Garcia-Sosa I, Alcantara D, Rodriguez-Fuentes G (2000) Silver supported on natural Mexican zeolite as an antibacterial material. Microporous Mesoporous Mater 29:431–444
Shameli K, Ahmad MB, Zargar M, Yunus WMZ, Ibrahim NA (2011a) Fabrication of silver nanoparticles doped in the zeolite framework and antibacterial activity. Int J Nanomedicine 6:331–341
Shameli K, Ahmad MB, Zargat M, Yunus WMZ, Rustaiyan A, Ibrahim NA (2011b) Synthesis of silver nanoparticles in montmorillonite and their antibacterial behaviour. Int J Nanomedicine 6:581–590
Silvestry-Rodriguez N, Sicairos-Ruelas E, Gerba CP, Bright KR (2007) Silver as a disinfectant. Rev Environ Contam T 191:23–45
Spain A (2003) Implications of microbial heavy metal tolerance in the environment. Rev Undergrad Res 2:1–6
Sprynskyy M, Buszewski B, Terzyk AP, Namiesnik J (2006) Study of the selection mechanism of heavy metal (Pb2+, Cu2+, Ni2+, and Cd2+) adsorption on clinoptilolite. J Colloid Interface Sci 304:21–28
Sprynskyy M, Golembiewski R, Trykowski G, Buszewski B (2010) Heterogeneity and hierarchy of clinoptilolite porosity. J Phys Chem Solids 71:1269–1277
Top A, Ulku S (2004) Silver, zinc and copper exchange in an Na-clinoptilolite and resulting effect on antibacterial activity. Appl Clay Sci 27:13–19
Van Grieken R, Marugán J, Pablos C, Furones L, López A (2010) Comparison between the photocatalytic inactivation of Gram-positive E. faecalis and Gram-negative E. coli faecal contamination indicator microorganisms. Appl Catal B Environ 100:212–220
Wang S, Peng Y (2010) Natural zeolites as effective adsorbents in water and wastewater treatment. Chem Eng J 156:11–24
WHO (2011) Guidelines for drinking-water quality, 4th edn. World Health Organization, Geneva
Author information
Authors and Affiliations
Corresponding author
Additional information
Responsible editor: Gerald Thouand
Electronic supplementary material
Below is the link to the electronic supplementary material.
Figure
(DOCX 34 kb)
Rights and permissions
About this article
Cite this article
Akhigbe, L., Ouki, S., Saroj, D. et al. Silver-modified clinoptilolite for the removal of Escherichia coli and heavy metals from aqueous solutions. Environ Sci Pollut Res 21, 10940–10948 (2014). https://doi.org/10.1007/s11356-014-2888-6
Received:
Accepted:
Published:
Issue Date:
DOI: https://doi.org/10.1007/s11356-014-2888-6








